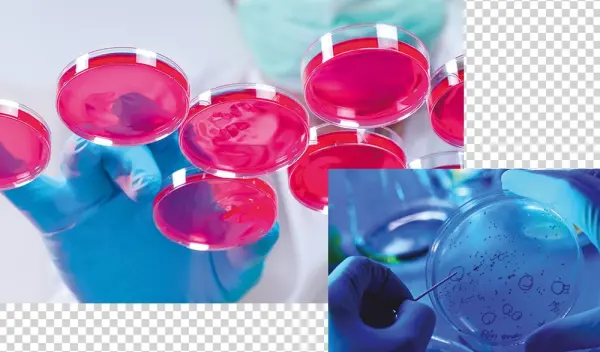

Agar - Cell

Accessories

Animals

Electronics

Festivals

Food

Nature

People

Social

Transportation

Vector
Agar - Cell
Description
Agar - Cell is a high-quality image available in full resolution.
Perfect for use in websites, blogs, presentations, and creative design projects.
This photo captures the essence of Agar - Cell with clarity and detail.
Suitable for personal and commercial use with no attribution required.
Explore more visuals related to
cell phone icon, jail cell, cell phone vector, hell in a cell, cell phone, perfect cell.
PNG keywords
PNG info
Dimensions
1000x586px
Filesize
778.77KB
MIME type
Image/png
Resize PNG
width(px)
height(px)
Non-commercial use, DMCA
Relevant png images